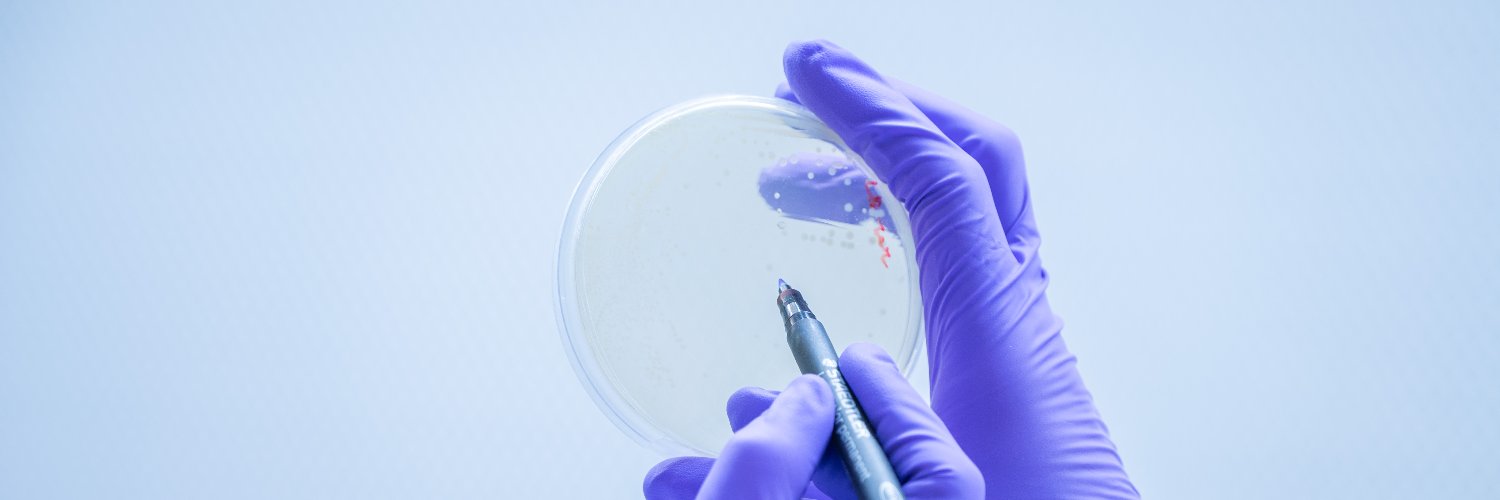
Institute for Advanced Chemistry of Catalonia banner

Institute for Advanced Chemistry of Catalonia retweetledi

🔦Luz contra el #cáncer
🗣️“Diseñamos moléculas que, tras ser estimuladas con luz, liberan el fármaco activo y actúan sobre las células tumorales”
🔬Un estudio en ratones muestra su eficacia para eliminar células tumorales resistentes en #cáncermama👇
x.com/IQAC_CSIC/stat…
Institute for Advanced Chemistry of Catalonia@IQAC_CSIC
🆕 Investigadores del @IQAC_CSIC y @VHIR_ desarrollan una estrategia basada en luz para activar una molécula y eliminar células tumorales resistentes en cáncer de mama. Los resultados muestran el potencial para actuar de forma precisa y selectiva. 👉 iqac.csic.es/es/una-estrate…
Español